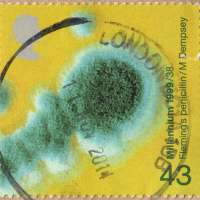

STAMP PHILATELY
Malaysia : Postal Cover from Great Britain (2014)
Malaysia : Postal Cover from Great Britain (2014)
Received on 19 November 2014
COMMENTS
NEW COMMENT
|
The following text must accompany any text or photo taken from this page and limited use for non-commercial purposes only.
Texts and Images were taken from and courtesy of Exonumi.com
URL: http://www.exonumi.com/publish-SP.1.1203
|
|